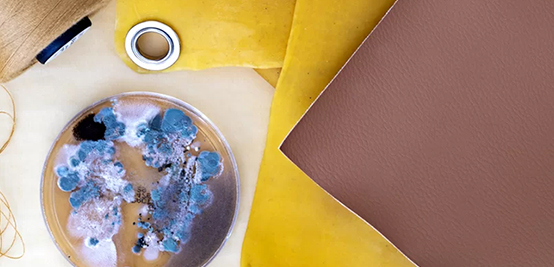

#Recycling / Circular Economy

ADVANSA launches ADVA®tex: A new step toward textile-to-textile recycling
ADVANSA has introduced ADVA®tex, a new filling fibre made entirely from recycled pre-consumer textile waste, positioning the material as a significant step forward in textile-to-textile (T2T) recycling. The fibre is designed for use in duvets, pillows, mattresses, and furniture applications and is available in three versions.